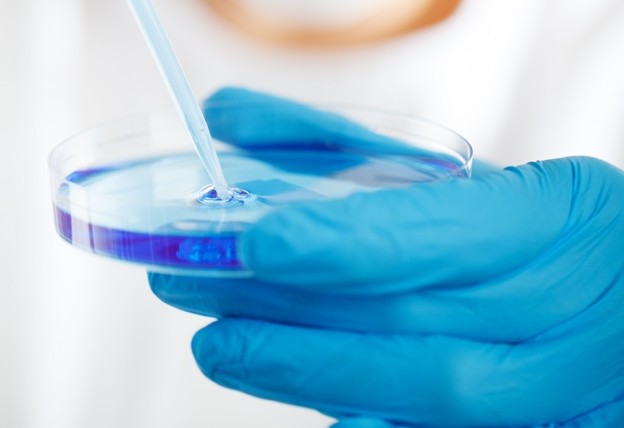

Pohrana podataka
Ostvarena pohrana digitalnih fotografija u DNK
Znanstvenici konvertirali jedinice i nule digitalnih podataka u 4 osnovna DNK bloka.
Ovih dana znanstvenici Sveučilišta u Washingtonu i njihovi kolege iz Microsoft Researcha objavili su znanstveni rad u kojem opisuju kako su prvi puta uspješno došli u mogućnost pohrane digitalnih fotografija u DNK.
Mada sama ideja o pohrani podataka u DNK nije nova, ovoga puta su znanstvenici uspješno enkodirali digitalne podatke iz datoteka fotografija u sekvencu nukleotida, monomerske jedinice nukleinskih kiselina i posrednike u reakcijama prijenosa energije u stanicama, koje su se nalazile unutar sintetskih DNK uzoraka, te su potom uspjeli izvesti obrnuti postupak i povratiti podatke bez ikakvih gubitaka.
Kako bi im to uspjelo, znanstvenici su razvili tehniku koja im je omogućila pohranu digitalnih slika unutar DNK u testnoj epruveti, te su započeli konvertirati duge nizove jedinica i nula u digitalne podatke unutar četiri osnovne sekvence DNK, adenina, guanina, citozina i timina.
Digitalni podaci su tada rastavljeni na dijelove i pohranjeni sintetiziranjem ogromnog broja sićušnih molekula DNK, koje se mogu dehidrirati i sačuvati stotinama godina.
Kako bi se podaci povratili, znanstvenici su enkodirali ekvivalent zip kodova (poštanskih brojeva) i uličnih adresa u DNK sekvence, što im je omogućilo da jednostavno pronađu ono što im treba. Zahvaljujući tehnikama sekvencioniranja DNK, nakon toga su mogli čitati podatke i konvertirati ih nazad u prvobitno stanje korištenjem uličnih adresa za rearanžiranje podataka.
Osim digitalnih slika, ovom su metodom uspjeli pohraniti i povratiti podatke i iz videa, te navode kako su uspjeli postići sažimanje masivnih količina podataka koji bi mogli ispuniti jedan trgovački centar u veličinu kocke šećera, a najviše pažnje su posvetili konvertiranju jedinica i nula u sekvence DNK (As, Gs, Cs i Ts), jer ako to ne bi izveli kako treba, dolazilo bi do obilja grešaka.
Znanstvenici navode da se svi sustavi za pohranu digitalnih podataka koje danas koristimo, poput flash memorije, tvrdih diskova, magnetskih i optičkih medija, degradiraju već nakon nekoliko godina, dok bi korištenje ove metode DNK pohrane, naše podatke moglo čuvati stoljećima, pa čak i tisućljećima.
"Ovaj multidisciplinarni pristup je ono što čini projekt uzbudljivim", navodi Karin Strauss, znanstvenica u Microsoft Researchu i profesorica računalnih znanosti i inženjerstva. "Time smo pomakli granice onoga što se može činiti s DNK, a to je rezultiralo sustavom pohrane jedinstvene gustoće i trajnosti.
Izvor: Microsoft Research
Učitavam komentare ...